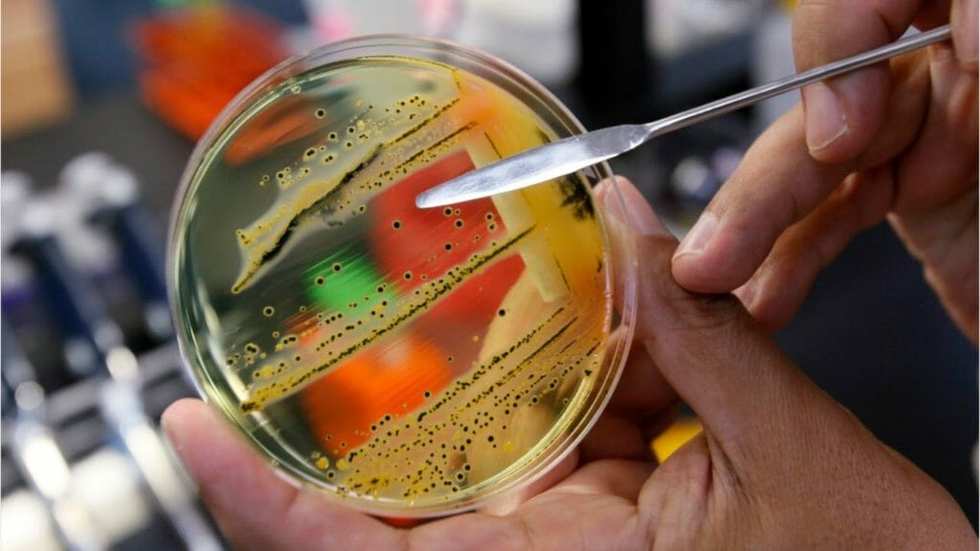

[DIGEST: BBC, CNN (1, 2), CNBC, CDC, NBC]
There are two kinds of STDs: those that can be successfully treated and those that cannot. Now gonorrhea, a sexually transmitted disease that has typically been cured through a course of antibiotics, is moving into the untreatable camp. Neisseria gonorrhoeae, the bacterium that causes gonorrhea, is developing resistance to the only antibiotics that can treat it.
"It's at a critical stage. We're at our last class of antibiotics," said Thomas Hiltke, a program officer at the National Institute of Allergies and Infectious Diseases Sexually Transmitted Infections Branch.
That class, cephalosporins, has been reliably used for decades to treat gonorrhea infections. However, in countries including Japan, Spain, and France, doctors are seeing strains of gonorrhea that are resistant to cephtriaxone, considered the last line of defense against the disease.
"The bacteria that cause gonorrhea are particularly smart. Every time we use a new class of antibiotics to treat the infection, the bacteria evolve to resist them," said Teodora Wi, a human reproduction specialist at the WHO.
Researchers with a group that tracks STDs found that in 77 countries that participate in a global gonorrhea tracking program, more than 90 percent report some kind of antibiotic-resistant gonorrhea.
"This has been a real hard issue for people to take issue seriously," said Manica Balasegaram, head of the Global Antibiotic Research and Development Partnership, a joint initiative of WHO and the Drugs for Neglected Diseases Initiative. "It's not seen as a killer disease, but it's a big public health threat."
Symptoms of gonorrhea include painful urination, itching, and a pus-like discharge from the penis, vagina or anus. It can also infect the throat. It is a leading cause of infertility for men and women. More worrisome, many people experience no symptoms at all, but can still infect others. Pregnant women who are unknowingly infected with the disease are at risk of premature birth and can pass it on to their newborns, who will suffer lifelong complications from the disease. About 2,300 people a year die from gonorrhea. About 78 million adults a year contract the disease. Around 400,000 Americans were diagnosed with gonorrhea in 2015. Additionally, gonorrhea and chlamydia infections can also make it easier to become infected with HIV.
Over the past decade, oral sex has fueled drug-resistant forms of the disease, say the researchers. Doctors often mistake gonorrhea-related throat infections for strep throat, and they prescribe the wrong antibiotics to treat it. When a throat infection caused by oral sex is misidentified as strep and treated with the wrong drugs. "This fuels more resistance," said Dr. Vicky Enne, a clinical microbiologist at UCL in the UK.
It’s not just gonorrhea, either. Three common STDs, chlamydia, gonorrhea and syphilis, have also been identified as drug resistant. As STD infection rates rise, this poses a serious public health threat.
Gonorrhea was named one of the 12 bacteria that pose the greatest threat to human health earlier in 2017, in a call to researchers to develop new antibiotics. Better rapid diagnostics tests would also help prevent drug resistance.
As infection rates escalate around the world, researchers are considering another way to bypass drug resistance: a vaccine to prevent infection in the first place. A vaccine called MeNZB was developed to control a meningitis epidemic in New Zealand from 2004 to 2006. Although the vaccine is no longer available, researchers have found that people vaccinated with MeNZB were 31 percent less likely to get gonorrhea than those who weren't. Now scientists are looking at ways to develop a vaccine against gonorrhea based on the effects of MeNZB.
"The emergence of completely drug-resistant gonorrhoea is a major concern," said Dr. Helen Petousis-Harris, lead author of the new study and a senior lecturer at the University of Auckland. “Given the emergence of drug resistance, a vaccine may be our only avenue.”

@madswellness/TikTok
@madswellness/TikTok
@madswellness/TikTok
@madswellness/TikTok
@madswellness/TikTok
@madswellness/TikTok
@madswellness/TikTok
@madswellness/TikTok
@madswellness/TikTok
@madswellness/TikTok
@madswellness/TikTok
@vanellimelli030/TikTok
@vanellimelli030/TikTok
@vanellimelli030/TikTok
@vanellimelli030/TikTok
@vanellimelli030/TikTok
@vanellimelli030/TikTok
@vanellimelli030/TikTok
@vanellimelli030/TikTok
@vanellimelli030/TikTok
@vanellimelli030/TikTok
@vanellimelli030/TikTok
@anissahm15/TikTok
@anissahm15/TikTok
@anissahm15/TikTok
@anissahm15/TikTok
@anissahm15/TikTok
@anissahm15/TikTok
@anissahm15/TikTok
@anissahm15/TikTok
@anissahm15/TikTok
@anissahm15/TikTok
@anissahm15/TikTok
@anissahm15/TikTok
@anissahm15/TikTok
@anissahm15/TikTok
@anissahm15/TikTok
@hustleb***h/TikTok
@hustleb***h/TikTok
@hustleb***h/TikTok
@hustleb***h/TikTok
@hustleb***h/TikTok
@hustleb***h/TikTok
@hustleb***h/TikTok